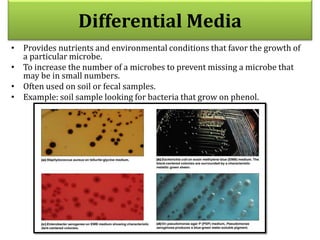
Differential Media
• Provides nutrients and environmental conditions that favor the growth of
a particular microbe.
• To increase the number of a microbes to prevent missing a microbe that
may be in small numbers.
• Often used on soil or fecal samples.
• Example: soil sample looking for bacteria that grow on phenol.

The document provides an overview of microbial growth, specifically detailing the phases of growth such as lag, log, stationary, and decline, along with factors influencing these phases. It discusses methods for measuring microbial populations, including direct (e.g., plate counts, microscopic counts) and indirect (e.g., turbidity, metabolic activity) techniques. Additionally, it outlines the physical and chemical requirements for microbial growth, including temperature, pH, moisture, and nutrient content.